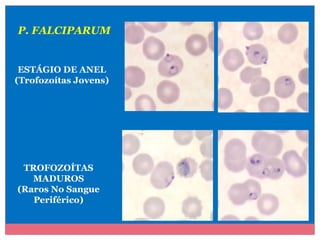
P. FALCIPARUM

ESTÁGIO DE ANEL
(Trofozoítas Jovens)

TROFOZOÍTAS
MADUROS
(Raros No Sangue
Periférico)

Este documento discute a malária, uma doença parasitária transmitida por mosquitos do gênero Anopheles. A malária é causada por parasitas do gênero Plasmodium e é uma das doenças que mais causa problemas de saúde em todo o mundo. O documento descreve o ciclo de vida do parasita, os sintomas da doença, formas de diagnóstico e espécies de Plasmodium que infectam humanos.